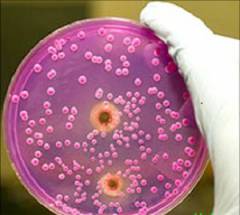

Строение лимфатических сосудов и лимфоузлов
Лимфатическая система — важная часть сосудистой системы организма. Она участвует в обмене веществ и защищает от микроорганизмов и инородных частиц.
Состав лимфатической системы:
- селезенка;
- лимфатическая жидкость (лимфа);
- лимфатические сосуды;
- лимфатические узлы.
Врачи отмечают, что лимфаденит является воспалением лимфатических узлов, которое может быть вызвано инфекциями, травмами или даже злокачественными процессами. Основными симптомами являются увеличение и болезненность лимфоузлов, а также общие признаки воспаления, такие как повышение температуры и слабость. Важно, что диагностика включает не только физикальное обследование, но и лабораторные исследования, такие как анализ крови и, при необходимости, биопсия. Лечение зависит от причины лимфаденита: в случае бактериальной инфекции могут назначаться антибиотики, а при вирусной — симптоматическая терапия. Врачам важно своевременно выявить и устранить первопричину, чтобы избежать осложнений и обеспечить быстрое восстановление пациента.

Селезенка
В процессе эмбрионального развития в селезенке формируются кровяные клетки. После рождения кроветворение в этом органе значительно снижается, и селезенка становится важным элементом лимфатической системы, где происходит дифференцировка лимфоцитов, что подразумевает приобретение ими специфических функций.
Лимфоциты — это один из видов лейкоцитов, или белых кровяных клеток, которые обеспечивают иммунную защиту организма от внешних и внутренних угроз. Эти клетки формируются в красном костном мозге, расположенном в тазу, позвонках, ребрах, грудине и других костях. Незрелые лимфоциты поступают из костного мозга в кровоток и затем направляются в селезенку, где завершается их дифференцировка.
| Причина лимфаденита | Симптомы и признаки | Диагностика и лечение |
|---|---|---|
| Инфекции (бактериальные, вирусные, грибковые): стрептококки, стафилококки, вирусы мононуклеоза, ВИЧ, туберкулез, токсоплазмоз | Увеличение лимфатических узлов, болезненность при пальпации, покраснение кожи над узлом, повышение температуры тела, общая слабость, головная боль, озноб | Физикальный осмотр, анализ крови (общий, биохимический), анализ мочи, бактериологический посев, ПЦР-диагностика, УЗИ лимфатических узлов, биопсия лимфатического узла. Лечение зависит от причины: антибиотики (при бактериальной инфекции), противовирусные препараты (при вирусной инфекции), противогрибковые препараты (при грибковой инфекции), симптоматическая терапия (жаропонижающие, обезболивающие). |
| Аутоиммунные заболевания: ревматоидный артрит, системная красная волчанка | Увеличение лимфатических узлов, часто безболезненное, симптомы основного заболевания | Анализ крови на аутоантитела, биопсия лимфатического узла, лечение основного заболевания (иммуносупрессивная терапия, глюкокортикоиды). |
| Злокачественные новообразования: лимфома, лейкемия, метастазы опухолей | Увеличение лимфатических узлов, часто безболезненное, увеличение может быть значительным, появление других симптомов, связанных с основным заболеванием | Анализ крови (общий, биохимический), биопсия лимфатического узла, КТ, МРТ, ПЭТ-КТ. Лечение зависит от типа и стадии онкологического заболевания (химиотерапия, лучевая терапия, хирургическое вмешательство, таргетная терапия). |
| Другие причины: аллергические реакции, реакция на укусы насекомых, саркоидоз | Увеличение лимфатических узлов, возможно покраснение и зуд кожи, симптомы аллергии или основного заболевания | Анализ крови (общий, биохимический), кожные пробы, биопсия лимфатического узла. Лечение зависит от причины: антигистаминные препараты (при аллергии), кортикостероиды (при воспалении). |
Лимфа
Процесс образования лимфы происходит во всех тканях организма благодаря переходу белков и жидкости из кровеносных капилляров в лимфатические. Артерии, доставляющие кровь к органам, разветвляются и уменьшаются в диаметре, образуя капилляры — самые мелкие сосуды. На уровне капилляров часть жидкости и небольшое количество белков покидают сосудистое русло (фильтрация) и проникают в межклеточное пространство. Большая часть отфильтрованной жидкости возвращается в кровеносные капилляры, образующие венулы и вены, что обеспечивает отток венозной крови к сердцу.
Некоторая доля белков и около 10% жидкости из межклеточного пространства не возвращаются в кровеносную систему, а попадают в лимфатические капилляры. В результате образуется лимфа, которая, помимо белков и плазмы, содержит микроэлементы, жиры, углеводы и клеточные компоненты (в основном лимфоциты).
Лимфаденит — это воспаление лимфатических узлов, которое может быть вызвано инфекциями, травмами или даже онкологическими заболеваниями. Люди часто отмечают, что основными симптомами являются болезненность, отек и покраснение в области пораженного узла. Иногда лимфаденит сопровождается общими признаками, такими как температура, слабость и потливость. Диагностика включает в себя физикальное обследование, анализы крови и, в некоторых случаях, ультразвуковое исследование. Лечение зависит от причины воспаления: в случае бактериальной инфекции могут назначаться антибиотики, а при вирусной — симптоматическая терапия. Важно не игнорировать симптомы и обратиться к врачу, так как своевременная диагностика и лечение могут предотвратить осложнения.

Лимфатические сосуды
При объединении лимфатических капилляров образуются крупные лимфатические сосуды. Через них лимфатическая жидкость отводится от тканей к лимфатическим узлам, связанным с определёнными органами или участками тела.
Из лимфоузлов выходят выносящие лимфатические сосуды, которые соединяются, формируя крупные лимфатические стволы и протоки. Эти структуры переносят лимфатическую жидкость в крупные вены, возвращая её в системный кровоток.
В человеческом организме выделяют несколько основных лимфатических протоков:
- Грудной лимфатический проток – собирает лимфу от нижних конечностей, органов таза, брюшной полости и левой части грудной клетки.
- Левый подключичный ствол – отвечает за сбор лимфы от левой руки.
- Левый яремный ствол – собирает лимфу от левой стороны головы и шеи.
- Правый лимфатический проток – формируется из нескольких лимфатических стволов и собирает лимфу от правой стороны головы, шеи, правой половины грудной клетки и правой руки.
Лимфатические узлы
Лимфатические узлы — это небольшие округлые или овальные образования размером от нескольких миллиметров до 1-2 сантиметров, расположенные вдоль лимфатических сосудов, которые транспортируют лимфу от органов и тканей. Их поверхность защищена соединительнотканной капсулой, под которой находится лимфоидная ткань, насыщенная лимфоцитами.
Лимфоциты формируются в лимфатических узлах уже на этапе эмбрионального развития. Их основная задача — распознавать чуждые вещества, такие как вирусы, бактерии и опухолевые клетки, а также активировать защитные механизмы организма для их нейтрализации.
Лимфа, поступающая в лимфатические узлы, медленно проходит через узкие щелевидные пространства, называемые синусами. Этот процесс очищает лимфу от инородных частиц и обеспечивает взаимодействие лимфоцитов с чуждыми агентами.
Основная функция лимфатических узлов — предотвращение распространения патологических процессов в организме. Это достигается благодаря нескольким группам лимфоузлов, которые фильтруют лимфу из различных участков тела, служа барьером для инфекций и не позволяя чуждым антигенам попадать в органы и ткани.
К основным группам лимфатических узлов в организме человека относятся:
- лимфоузлы головы и шеи (шейные, подчелюстные, затылочные и другие);
- лимфоузлы грудной полости;
- лимфоузлы брюшной полости и живота (брыжеечные, подвздошные, тазовые);
- лимфоузлы нижних конечностей (паховые, подколенные);
- лимфоузлы верхних конечностей (подмышечные, локтевые).
Каждая группа лимфоузлов собирает лимфу от определенных тканей и органов. Прежде чем попасть в системный кровоток, лимфатическая жидкость проходит через несколько лимфатических узлов, очищаясь от инородных частиц и обогащаясь лимфоцитами, которые затем распределяются по всем тканям и органам, выполняя защитные функции.

Развитие воспалительного процесса в лимфатическом узле
Если в органе обнаруживаются чуждые агенты (вирусы, бактерии, токсины), они проникают в лимфатические капилляры с межтканевой жидкостью и направляются в региональные лимфатические узлы. Инфекция может попасть в лимфатические узлы через кровь (гематогенным путем) или из соседних тканей (контактным путем). В редких случаях патогенные микроорганизмы проникают из окружающей среды (например, при травме лимфоузла).
В лимфатических узлах чуждые антигены взаимодействуют с лимфоцитами, что активирует их и приводит к выработке специфических антител, инициируя воспалительный процесс. Из кровотока в лимфатический узел поступает множество лейкоцитов, которые способствуют воспалению и уничтожению чуждых веществ.
Клетки, участвующие в воспалительном процессе:
- Лимфоциты. Первые клетки, контактирующие с чуждыми антигенами, выделяющие специфические антитела для их нейтрализации и регулирующие активность других лейкоцитов.
- Нейтрофилы. Лейкоциты, способные к фагоцитозу (поглощению фрагментов чуждых микроорганизмов). После поглощения нейтрофилы погибают, выделяя биологически активные вещества и остатки микроорганизмов, что приводит к образованию гноя. Некоторые из этих веществ (серотонин, гистамин) расширяют сосуды, улучшая местное кровообращение и привлекая больше лейкоцитов, что поддерживает воспалительный процесс.
- Эозинофилы. Эти клетки защищают организм от паразитов, поглощают фрагменты бактерий и вырабатывают специфические антитела против чуждых микроорганизмов.
- Базофилы. Основные клетки, ответственные за аллергические реакции. Они выделяют биологически активные вещества, способствующие развитию и поддержанию воспалительного процесса.
- Моноциты. Очищают воспаленный очаг от некротических масс и чуждых веществ. Способны к фагоцитозу, поглощая крупные микроорганизмы, погибшие лимфоциты и части разрушенных тканей.
Миграция лейкоцитов в воспаленный участок и активация лимфоцитов в воспаленных лимфоузлах приводят к гиперплазии лимфоидной ткани, что проявляется в увеличении размера лимфатического узла. Выделение биологически активных веществ вызывает повышенную чувствительность и болезненность воспаленной области.
Когда воспаляются лимфоузлы?
Как уже упоминалось, основная функция лимфатических узлов — предотвращение распространения заболеваний. Инфекционные агенты задерживаются и уничтожаются лимфоцитами. Однако при большом количестве чуждых микроорганизмов лимфоциты могут не справляться, что приводит к их размножению и увеличению лимфоузлов.
Причины лимфаденита
Лимфаденит может быть вызван различными патогенными микроорганизмами.
В зависимости от типа инфекции лимфаденит делится на:
- неспецифический;
- специфический.
Неспецифический лимфаденит
Возникает из-за множества микроорганизмов с различной структурой и вирулентностью, но схожими механизмами развития.
Причины неспецифического лимфаденита:
- Бактерии и их токсины. Бактерии могут существовать в различных органах, вызывая их повреждение. Воспаление может быть вызвано стафилококками, стрептококками, кишечной палочкой и другими. Некоторые из них выделяют токсины, провоцирующие лимфаденит.
- Вирусы. Вирусы размножаются только внутри живых клеток. При заражении их ДНК проникает в клетку-хозяина, что приводит к производству новых вирусов. При разрушении зараженной клетки вирусы попадают в лимфатические капилляры и вызывают воспаление.
- Грибы. Некоторые виды грибов могут вызывать заболевания (микозы), в то время как другие являются нормальными обитателями кожи и слизистых оболочек и становятся патогенными при ослаблении иммунной системы.
Специфический лимфаденит
Возникает из-за попадания в лимфоузлы определенных микроорганизмов:
- микобактерии туберкулеза;
- бледная трепонема (возбудитель сифилиса);
- чумная палочка (возбудитель чумы);
- актиномицеты (вызывающие актиномикоз);
- бруцеллы (возбудители бруцеллеза);
- туляремийные бактерии (возбудители туляремии).
Эти микроорганизмы вызывают специфические изменения в лимфатических узлах.
Виды лимфаденита
Воспалительный процесс в лимфатических узлах может развиваться по-разному в зависимости от типа микроорганизма и его вирулентности.
В зависимости от скорости развития выделяют:
- Острый лимфаденит. Возникает при поражении лимфоузлов высоковирулентной инфекцией. Характеризуется быстрым воспалением, часто с общими симптомами (повышение температуры, слабость, головные боли). Без лечения может перейти в гнойную форму.
- Хронический лимфаденит. Развивается при заражении слабовирулентной инфекцией или как следствие недолеченного острого лимфаденита.
В зависимости от характера воспалительного процесса различают:
- Катаральный (простой) лимфаденит. Характерен для начальной стадии заболевания.
- Гиперпластический лимфаденит. Характеризуется разрастанием лимфоцитов и выраженной инфильтрацией лейкоцитами.
- Гнойный лимфаденит. Характеризуется нагноением и разрушением лимфатического узла.
Причины лимфаденита различных областей
Лимфа из разных участков тела собирается в различные группы лимфатических узлов. Инфекционное поражение определенной области проявляется воспалением соответствующих лимфоузлов.
Если регионарные лимфоузлы не справляются с защитной функцией, инфекционные агенты могут попасть в системный кровоток, что приведет к генерализованному лимфадениту.
Причины подчелюстного лимфаденита
Подчелюстные лимфоузлы расположены внутри от угла нижней челюсти и собирают лимфу от:
- кожи и мягких тканей лица;
- полости рта;
- десен и зубов;
- слюнных желез.
Инфекция в любой из этих областей может вызвать воспаление подчелюстных лимфоузлов.
Причины подчелюстного лимфаденита
| Инфекции кожи лица | * Травмы и ссадины. * Фурункул. * Карбункул. * Гидраденит. * Импетиго. * Рожистое воспаление. * Герпес. * Опоясывающий лишай. |
| Инфекции полости рта | * Гингивит. * Кариес. * Глоссит. * Инфекционный стоматит. |
| Инфекции слюнных желез | * Вирусные (свинка, цитомегалия). * Бактериальные (стафилококковые, стрептококковые). |
Причины шейного лимфаденита
Шейные лимфоузлы фильтруют лимфу от головы и шеи. Инфекционные процессы в этой области могут привести к воспалению шейных лимфоузлов.
Различают:
- Поверхностные. Собирают лимфу от кожи и мягких тканей.
- Глубокие. Отводят лимфу из внутренних органов шеи и полости носа, рта, уха.
Причины воспаления шейных лимфоузлов:
- Грибковые заболевания волосистой части головы.
- Отит.
- Тонзиллит.
- Фарингит.
- Ринит.
- Синусит.
- Инфекционный тиреоидит.
- Инфекционный мононуклеоз.
- Краснуха.
- Аденовирусная инфекция.
- Грипп.
- Нагноившиеся раны области головы и шеи.
Причины подмышечного лимфаденита
Подмышечные лимфоузлы собирают лимфу от кожи, мягких тканей и костей верхней конечности, а также от грудной клетки и молочной железы.
Причины воспаления подмышечных лимфатических узлов:
- Гнойно-воспалительные заболевания кожи верхней конечности.
- Нагноение порезов и ссадин.
- Грибковые поражения кожи.
- Остеомиелит костей руки.
- Панариций.
- Мастит.
Причины пахового лимфаденита
Паховые лимфатические узлы собирают лимфу от тканей нижней конечности и наружных половых органов.
Все инфекционные заболевания кожи, мягких тканей и костей могут вызывать воспаление паховых лимфоузлов.
Дополнительные причины:
- Гонорея.
- Баланопостит.
- Кольпит.
- Вульвит.
Симптомы лимфаденита различных областей
Проявления лимфаденита зависят от воспалительного процесса в лимфатических узлах и распространения инфекции.
Симптомы подчелюстного лимфаденита
- Увеличение лимфоузлов. Плотные, болезненные образования, не спаянные с окружающими тканями.
- Боль. Увеличивается по мере прогрессирования заболевания.
- Изменение кожных покровов. Покраснение и припухлость кожи над лимфоузлами.
- Нагноение лимфатических узлов. Плотные, неподвижные образования.
- Системные проявления. Повышение температуры, слабость, головные боли.
Симптомы шейного лимфаденита
- Увеличение шейных лимфатических узлов. Пальпируются на передней или боковой поверхности шеи.
- Боль. При пальпации и движениях головы.
- Изменение кожных покровов. Отечность и покраснение кожи.
- Ограничение движений. Сильная боль при поворотах головы.
Симптомы подмышечного лимфаденита
- Увеличение лимфатических узлов. Один или несколько увеличенных лимфоузлов.
- Боль. Выраженная болезненность в подмышечной области.
- Изменения кожи. Цвет кожи может оставаться неизменным, но при гнойном процессе становится багрово-красным.
- Нарушение движений рукой. Боль при движениях.
- Отеки рук. Из-за сдавливания вен.
Симптомы пахового лимфаденита
- Увеличение лимфоузлов. В области паховой связки.
- Боль. В очаге воспаления и внизу живота.
- Изменения кожи. Напряженность и отечность кожи.
- Отеки ног. Из-за нарушения оттока лимфы.
- Общее состояние. Обычно не изменено, если нет нагноения.
Диагностика лимфаденита
Диагностика лимфаденита основывается на симптомах, но сложнее выявить причину заболевания.
Используются:
- общий анализ крови;
- ультразвуковое исследование;
- рентгенологические методы;
- биопсия лимфатического узла.
Общий анализ крови (ОАК)
Позволяет выявить признаки воспалительных процессов. При лимфадените могут быть следующие изменения:
- Увеличение общего числа лейкоцитов.
- Увеличение нейтрофилов — характерно для бактериальной инфекции.
- Увеличение моноцитов — при вирусных и грибковых инфекциях.
- Увеличение лимфоцитов — указывает на вирусное заболевание.
- Увеличение скорости оседания эритроцитов (СОЭ).
Ультразвуковое исследование (УЗИ)
Позволяет определить:
- расположение, количество, форму, размеры и структуру лимфатических узлов;
- наличие воспаления в лимфатических сосудах;
- наличие гнойных осложнений.
Рентгенологические методы
Используются при подозрении на поражение глубокорасположенных лимфатических узлов.
Биопсия лимфатического узла
Инвазивный метод, связанный с удалением части воспаленного лимфоузла для исследования. Показания:
- Подозрение на опухолевую природу увеличения лимфоузла.
- Хронические лимфадениты.
- Подозрение на специфический лимфаденит.
Лечение лимфаденита
Лечение лимфаденита направлено на устранение первопричины и уменьшение воспалительного процесса.
К какому врачу обращаться?
При увеличении лимфатических узлов следует обратиться к семейному врачу. В зависимости от расположения лимфаденита могут понадобиться консультации:
- Оториноларинголога (ЛОРа) и/или стоматолога.
- Уролога.
- Терапевта.
- Дерматолога.
- Фтизиатра.
- Хирурга.
Основные направления в лечении:
- медикаментозное лечение;
- физиотерапия;
- народные методы;
- хирургическое лечение.
Медикаментозное лечение
Включает этиотропную и симптоматическую терапию.
| Симптоматическая терапия | ||||
| Группа препаратов | Представители | Механизм действия | Способы применения и дозировка | |
| Нестероидные противовоспалительные средства | Кеторолак | Угнетает фермент циклооксигеназу, уменьшая воспаление. | 5-10 мг 3-4 раза в день. | |
| Нимесулид (Нимесил) | Угнетает циклооксигеназу в очаге воспаления. | 100 мг 2 раза в сутки. | ||
| Антигистаминные препараты | Цетиризин | Блокирует H1-гистаминовые рецепторы, уменьшая отек. | 2,5 мг 2 раза в день для детей до 6 лет; 5 мг 2 раза в день для старших. | |
| Этиотропная терапия | ||||
| Антибактериальные препараты | Амоксиклав | Блокирует образование клеточной стенки бактерий. | 60 мг 3 раза в сутки для детей 1-2 лет; 300-500 мг 3 раза в сутки для взрослых. | |
| Цефтриаксон | Устойчив к бета-лактамазам, нарушает клеточные мембраны. | 20-80 мг/кг для детей; 1-2 г для взрослых. | ||
| Клиндамицин | Угнетает деление бактерий. | 3-6 мг/кг для детей; 150 мг каждые 6 часов для взрослых. | ||
| Противовирусные препараты | Ацикловир | Нарушает размножение вируса. | 200-500 мг 4-5 раз в сутки. | |
| Противогрибковые препараты | Флуконазол | Нарушает процессы роста грибов. | 200-400 мг 1 раз в сутки. |
Физиотерапия
Физиотерапия включает воздействие физическими факторами для облегчения состояния пациента и уменьшения воспаления.
Методы:
- УВЧ-терапия.
- Лазеротерапия.
- Гальванизация.
Народные методы лечения
Применяются для уменьшения симптомов воспаления и улучшения состояния. Используются в комплексе с антибактериальной терапией.
Наиболее распространенные методы:
- Прогревание лимфоузлов.
- Травяные сборы.
- Настойка эхинацеи.
Хирургические методы лечения
Применяются при гнойных осложнениях — абсцессе и аденофлегмоне. Включают вскрытие гнойного очага и дренирование.
Причины лимфаденита
Лимфаденит возникает из-за патогенных микроорганизмов, проникающих в лимфатические узлы.
В зависимости от типа инфекции лимфаденит делится на:
- неспецифический;
- специфический.
Неспецифический лимфаденит
Неспецифический лимфаденит возникает под воздействием различных микроорганизмов, которые имеют схожие механизмы развития и проявления.
Основные причины неспецифического лимфаденита:
- Бактерии и их токсины. Бактерии — живые клетки, способные размножаться в организме и вызывать вред. Воспаление лимфатических узлов может быть вызвано стафилококками, стрептококками, кишечной палочкой и другими микроорганизмами. Некоторые из них выделяют токсические вещества, способные спровоцировать лимфаденит.
- Вирусы. Вирусы состоят из фрагментов нуклеиновых кислот — ДНК или РНК, которые размножаются только внутри живых клеток. При вирусной инфекции ДНК вируса проникает в генетический аппарат клетки-хозяина, заставляя её производить новые вирусные частицы. При разрушении зараженной клетки вирусы высвобождаются и поражают соседние клетки. Часть вирусных фрагментов проникает в лимфатические капилляры, задерживаясь в регионарных лимфатических узлах и вызывая воспаление.
- Грибы. Грибы — особая группа микроорганизмов, схожих с бактериями, которые могут развиваться в организме. Существуют различные виды грибов (дрожжевые, плесневые и другие). Некоторые из них могут вызывать заболевания (микозы) при попадании в организм, в то время как другие являются нормальными обитателями кожи и слизистых оболочек, но могут стать патогенными при нарушении иммунной системы, например, при СПИДе.
Специфический лимфаденит
Специфический лимфаденит возникает при попадании в лимфоузлы определенных микроорганизмов.
Основные причины специфического лимфаденита:
- микобактерии туберкулеза;
- бледная трепонема (возбудитель сифилиса);
- чумная палочка (возбудитель чумы);
- актиномицеты (патогенные грибы, вызывающие актиномикоз);
- бруцеллы (возбудители бруцеллеза);
- туляремийные бактерии (возбудители туляремии).
Инфицирование этими микроорганизмами формирует специфическую клиническую картину для каждого заболевания. Патогены проникают в лимфатические узлы через лимфатическую систему, вызывая характерные изменения.
Виды лимфаденита
Воспалительный процесс в лимфатических узлах зависит от типа микроорганизма и его вирулентности.
По скорости прогрессирования воспаления выделяют:
- Острый лимфаденит. Возникает при воздействии высоковирулентной инфекции. Характеризуется быстрым и выраженным воспалением, часто с общими симптомами: повышением температуры, слабостью, головными и мышечными болями. Без лечения может перейти в гнойную форму, что приведет к гнойному расплавлению лимфатического узла и поражению окружающих тканей, включая абсцесс или аденофлегмону.
- Хронический лимфаденит. Возникает при заражении слабовирулентной инфекцией или как следствие недолеченного острого лимфаденита, когда воспаление становится затяжным. Часто наблюдается при специфических лимфаденитах, таких как туберкулезный или сифилитический.
По характеру воспалительного процесса выделяют:
- Катаральный (простой) лимфаденит. Характерен для начальной стадии заболевания. Изменение проницаемости капилляров в лимфоузле приводит к выходу жидкой части крови в ткани. Наблюдается умеренная миграция лейкоцитов в область воспаления.
- Гиперпластический лимфаденит. Поздняя стадия заболевания, характеризующаяся увеличением количества лимфоцитов и выраженной инфильтрацией лейкоцитами, такими как нейтрофилы и эозинофилы.
- Гнойный лимфаденит. Последняя стадия бактериального лимфаденита, при которой происходит нагноение и разрушение лимфатического узла. Исходом может стать абсцесс — ограниченное пространство с гноем, или аденофлегмона — разлитой гнойный процесс, выходящий за пределы первоначального очага инфекции.
Причины лимфаденита различных областей
Лимфа из разных частей тела собирается в группы лимфатических узлов. Инфекционное поражение области проявляется воспалением соответствующих лимфоузлов.
Если лимфоузлы не справляются с защитной функцией (например, при тяжелом инфекционном заболевании или ослаблении иммунной системы), инфекционные микроорганизмы могут попасть в кровоток и распространиться на другие органы, что приведет к генерализованному лимфадениту (воспалению различных групп лимфоузлов по всему организму).
Подчелюстные лимфоузлы расположены внутри угла нижней челюсти, их количество составляет от 8 до 10.
Источники лимфы для подчелюстных лимфоузлов:
- кожа и мягкие ткани лица (нижние веки, щеки, нос, губы, подбородок);
- полость рта (слизистая оболочка неба, задняя часть языка);
- десны и зубы;
- поднижнечелюстные и подъязычные слюнные железы.
Инфекция в любой из этих зон может привести к воспалению подчелюстных лимфоузлов.
Причины возникновения подчелюстного лимфаденита
| Инфекции кожи лица | * Травмы и ссадины на лице – могут стать входными воротами для патогенных микроорганизмов. * Фурункул – гнойное воспаление волосяного фолликула, обычно вызванное стафилококками. * Карбункул – гнойное воспаление группы волосяных фолликулов и сальных желез. * Гидраденит – гнойное воспаление апокриновых потовых желез в коже крыльев носа и век. * Импетиго – инфекция, вызванная стрептококком, проявляющаяся мелкими гнойничками на лице. * Рожистое воспаление – острое инфекционное заболевание, вызванное гемолитическим стрептококком. * Герпес – вирусная инфекция, вызванная вирусом герпеса первого типа. * Опоясывающий лишай – вирусное заболевание, вызванное вирусом ветряной оспы, проявляющееся сыпью по ходу нервных стволов. |
| Инфекции полости рта | * Гингивит – инфекционное воспаление десен, вызванное стафилококками и некоторыми грибами (актиномицетами). * Кариес – разрушение зубной ткани, в основном вызванное стафилококками и стрептококками. * Глоссит – воспаление языка из-за травм и заражения микроорганизмами ротовой полости. * Инфекционный стоматит – воспаление слизистой оболочки рта, вызванное бактериями, вирусами или грибами. |
| Инфекции слюнных желез | * Вирусные инфекции – эпидемический паротит (свинка), цитомегалия (вызываемая цитомегаловирусом). * Бактериальные инфекции – стафилококковые, стрептококковые и другие. |
В шейных лимфоузлах происходит фильтрация лимфы от головы и шеи, что делает их уязвимыми к инфекциям в этой области, вызывающим воспаление.
В шейной области выделяют несколько групп лимфоузлов:
- Поверхностные. Собирают лимфу от кожи и мягких тканей шеи и головы (кроме мышц).
- Глубокие. Отводят лимфу от внутренних органов шеи (глотка, гортань, трахея, верхняя часть пищевода, щитовидная железа и мышцы шеи), а также из полости носа, рта и уха. В них впадают лимфатические сосуды, выводящие лимфу из подчелюстных и других мелких лимфоузлов. Инфекции в этих областях могут привести к шейному лимфадениту, особенно при нарушении барьерной функции подчелюстных лимфоузлов.
Воспаление шейных лимфоузлов может быть вызвано также:
- Грибковыми инфекциями волосистой части головы – трихофития, микроспория, парша.
- Отитом – воспалением уха, вызванным патогенными микроорганизмами (пневмококками, стафилококками).
- Тонзиллитом – воспалением миндалин из-за патогенных бактерий или вирусов.
- Фарингитом – инфекционным воспалением слизистой глотки.
- Ринитом – воспалением слизистой носа.
- Синуситом – воспалением придаточных пазух носа (гайморит, фронтит, сфеноидит, этмоидит).
- Инфекционным тиреоидитом – воспалением щитовидной железы, вызванным вирусами или бактериями.
- Инфекционным мононуклеозом – вирусным заболеванием, поражающим шейные и другие группы лимфоузлов.
- Краснухой – вирусным заболеванием, вызывающим воспаление шейных и других лимфоузлов.
- Аденовирусной инфекцией – простудными заболеваниями верхних дыхательных путей, вызванными аденовирусами.
- Гриппом – острой респираторной вирусной инфекцией.
- Нагноившимися ранами в области головы и шеи.
Подмышечные лимфоузлы делятся на поверхностные и глубокие. Они собирают лимфатическую жидкость от кожи, мягких тканей и костей верхних конечностей, а также от верхней части живота, грудной клетки и молочной железы.
Воспаление подмышечных лимфатических узлов может быть вызвано:
- Гнойно-воспалительными заболеваниями кожи верхних конечностей – фурункулы, карбункулы, гидраденит, импетиго и рожистое воспаление.
- Нагноением порезов и ссадин в области рук, груди и верхней части живота.
- Грибковыми инфекциями кожи – споротрихоз, трихофития и микроспория.
- Остеомиелитом костей руки – воспаление костной ткани, вызванное гноеродными микроорганизмами.
- Панарицием – гнойно-воспалительный процесс в мягких тканях пальцев рук, затрагивающий сухожилия, кости и суставы.
- Маститом – воспаление молочной железы у женщин, чаще всего в период грудного вскармливания.
Паховые лимфатические узлы собирают лимфу от нижних конечностей, наружных половых органов, промежности, нижней части живота и спины.
Инфекционные заболевания кожи, мягких тканей и костей могут вызывать воспаление паховых лимфоузлов, если лимфа из зараженной области попадает в них.
Воспаление паховых лимфоузлов может быть вызвано:
- Гонорея – инфекция, вызываемая гонококком, передающаяся половым путем и проявляющаяся гнойным воспалением слизистых наружных половых органов (чаще у мужчин, реже у женщин).
- Баланопостит – воспаление кожи головки полового члена и крайней плоти, возникающее из-за различных инфекционных агентов (обычно связано с недостаточной гигиеной).
- Кольпит – инфекционное воспаление слизистой влагалища.
- Вульвит – инфекционное воспаление наружных женских половых органов.
Симптомы лимфаденита различных областей
Симптомы лимфаденита связаны с воспалением лимфатических узлов и распространением инфекции в организме.
Симптомы подчелюстного лимфаденита
Проявления заболевания зависят от размеров лимфоузлов и особенностей воспалительного процесса.
Симптомы подчелюстного лимфаденита:
- Увеличение лимфоузлов в области подбородка. При пальпации лимфоузлы ощущаются как плотные болезненные образования округлой или овальной формы, расположенные в подчелюстной зоне с одной или обеих сторон, легко смещающиеся под кожей. Размеры варьируются от нескольких миллиметров на ранних стадиях до нескольких сантиметров в гиперпластической фазе. Часто можно прощупать воспаленные лимфатические сосуды – тонкие, плотные нити, отходящие от пораженного лимфоузла.
- Боль. На начальных этапах наблюдается легкая болезненность при нажатии на подчелюстную область. С прогрессированием болезни боль усиливается и становится более выраженной при движениях челюсти (например, во время разговора или еды), а также может проявляться в состоянии покоя.
- Изменения кожи. На ранних стадиях кожа над лимфоузлами может оставаться неизменной. По мере развития воспаления наблюдаются покраснение и отек кожи в области воспаления, что связано с расширением и повышением проницаемости мелких сосудов. Также может отмечаться местное повышение температуры (на 1-2 градуса выше нормальной).
- Нагноение лимфатических узлов (при бактериальной инфекции). В гнойной стадии лимфоузлы могут сливаться друг с другом и с окружающими тканями, превращаясь в плотные и неподвижные образования. Кожа над воспаленным участком становится ярко-красной, напряженной и отечной. При пальпации и в состоянии покоя ощущается сильная болезненность, что ограничивает движения нижней челюсти и шеи.
- Системные проявления. При распространении инфекции за пределы лимфоузлов может наблюдаться общее повышение температуры тела до 38-40ºС, а также слабость, сонливость, мышечные и головные боли.
Симптомы шейного лимфаденита
Проявления заболевания зависят от размеров и расположения лимфоузлов, а также особенностей воспалительного процесса.
Симптомы шейного лимфаденита:
- Увеличение лимфатических узлов на шее. Узлы могут быть обнаружены на передней и боковой части шеи, а также над ключицей. При пальпации они проявляют признаки воспаления, аналогичные воспаленным подчелюстным узлам. При воспалении поверхностных лимфоузлов могут прощупываться воспаленные лимфатические сосуды.
- Болевые ощущения. Наблюдается болезненность при пальпации, а также при поворотах головы, разговоре, жевании и глотании.
- Изменения кожи. Отечность и припухлость кожи в области воспаления. При гнойной форме кожа может краснеть и появляться небольшие гнойные прорывы. Общие симптомы могут включать повышение температуры до 40ºС, слабость, нарушения сна и головные боли.
- Ограничение подвижности. Болевой синдром на поздних стадиях заболевания вызывает сильную острую боль при поворотах или наклонах головы. Значительное увеличение глубоких лимфатических узлов может сжимать органы шеи – голосовые связки, трахею, пищевод и крупные сосуды, что проявляется изменением голоса, затруднением дыхания и нарушением глотания.
Симптомы подмышечного лимфаденита
Проявления подмышечного лимфаденита зависят от активности воспалительного процесса в лимфоузлах. Увеличение лимфоузлов может сжимать окружающие ткани, нервы и сосуды, вызывая определенные симптомы.
Симптомы подмышечного лимфаденита:
- Увеличение лимфатических узлов. Обычно увеличивается один, реже – несколько лимфоузлов. При пальпации они имеют такие же характеристики, как и лимфадениты в других областях. Воспаленные лимфатические сосуды могут быть заметны при поражении поверхностных лимфоузлов.
- Боль. В подмышечной области возникает выраженная болезненность, которая может иррадиировать в плечо и боковую поверхность грудной клетки. Пациенты часто принимают вынужденное положение, отводя руку в сторону, чтобы снизить давление на воспаленные лимфоузлы и облегчить боль.
- Изменения кожи. При воспалении лимфоузлов цвет кожи может оставаться неизменным, но при гнойном процессе она становится багрово-красной, отечной и напряженной.
- Ограничение движений рукой. Боль усиливается при прикосновении к воспаленным лимфоузлам и движениях рукой, что ограничивает повседневную активность. Ограничение также может быть связано с увеличением лимфоузлов до нескольких сантиметров в диаметре.
- Отеки рук. Они могут возникнуть из-за сжатия крупных вен плеча и подмышечной области увеличенными лимфоузлами, что затрудняет отток жидкости и вызывает отек.
- Нарушение чувствительности в руке. Этот симптом может возникнуть при значительном увеличении лимфоузлов, сжимающих нервные стволы в подмышечной и плечевой областях. Это проявляется парестезиями, нарушением чувствительности, болями и двигательными расстройствами.
Симптомы пахового лимфаденита
Симптоматика заболевания зависит от локализации воспалительного процесса, размеров увеличенных лимфоузлов и степени сжатия окружающих тканей.
Основные симптомы пахового лимфаденита:
- Увеличение лимфоузлов в паху. Лимфоузлы в области паховой связки могут достигать нескольких сантиметров в диаметре. При пальпации они схожи с лимфоузлами, пораженными воспалением в других областях.
- Болевые ощущения. Паховый лимфаденит вызывает выраженную боль в области воспаления, нижней части живота и верхней части ноги. Боль усиливается при движении, затрудняя передвижение пациента.
- Изменения кожного покрова. Кожа над воспаленным участком становится напряженной и отечной. Если гнойный процесс отсутствует, цвет кожи может оставаться нормальным или слегка розоватым.
- Отечность ног на пораженной стороне. Этот симптом возникает из-за нарушения оттока лимфы через воспаленные лимфоузлы и значительного увеличения их размеров, что может сжимать крупные сосуды (включая бедренную вену, расположенную позади паховых лимфатических узлов).
- Общее состояние организма. Обычно остается стабильным, если не произошло нагноения лимфоузла. При нагноении может наблюдаться повышение температуры до 38–40ºС, общая слабость, боли в мышцах ног и живота, головные боли, учащенное сердцебиение и другие признаки интоксикации.
Диагностика лимфаденита
Лимфаденит легко определить по симптомам, но сложнее установить его причину, что важно для назначения лечения. Для этого применяются лабораторные и инструментальные методы исследования.
Для диагностики лимфаденита используются:
- общий анализ крови;
- ультразвуковое исследование;
- рентгенологические методы;
- биопсия лимфатического узла.
Общий анализ крови (ОАК)
Это один из первых анализов при подозрении на инфекцию. Он помогает выявить признаки воспалительных процессов и, при обширных инфекциях, обнаружить возбудителя и его чувствительность к противомикробным средствам.
При лимфадените в общем анализе крови могут наблюдаться следующие изменения:
- Повышение общего числа лейкоцитов — указывает на инфекционный процесс.
- Увеличение нейтрофилов — характерно для бактериальных инфекций.
- Рост моноцитов — наблюдается при вирусных и грибковых инфекциях, а также при туберкулезе и сифилисе.
- Повышение эозинофилов — связано с паразитарными, вирусными и бактериальными заболеваниями, включая туберкулез, сифилис и гонорею.
- Снижение моноцитов и эозинофилов — свидетельствует о гнойном процессе в организме (уменьшение этих клеток связано с их разрушением в очаге воспаления).
- Увеличение лимфоцитов — указывает на вирусное заболевание.
- Повышение скорости оседания эритроцитов (СОЭ) — говорит о наличии воспалительного процесса: чем выше значение, тем выраженнее воспаление.
Ультразвуковое исследование (УЗИ)
Это быстрый метод диагностики, не требующий специальной подготовки, безопасный и практически без противопоказаний, который можно выполнить в кабинете врача.
С помощью УЗИ можно определить:
- Расположение, количество, форму, размеры и структуру лимфатических узлов.
- Связь лимфоузла с окружающими тканями (наличие или отсутствие спаек).
- Признаки воспаления в лимфатических сосудах исследуемой области.
- Наличие гнойных осложнений лимфаденита (абсцесса, флегмоны).
- Очаги инфекции в внутренних органах.
Рентгенологические методы исследования
Применяются при подозрении на поражение глубоких лимфатических узлов, что наблюдается при системных инфекционных заболеваниях.
К рентгенологическим методам относятся:
- Обзорная рентгенография грудной клетки и живота. Этот метод помогает обнаружить увеличенные лимфоузлы (бронхолегочные, трахеальные и другие) и оценить состояние костей конечностей при остеомиелите. При специфическом туберкулезном лимфадените можно выявить очаги туберкулеза в легких.
- Компьютерная томография — современный метод, который позволяет точно установить размеры, расположение и форму воспаленных лимфоузлов, а также наличие абсцессов или аденофлегмоны и степень распространения гнойного процесса в затронутой области.
Биопсия лимфатического узла
Инвазивный метод диагностики, связанный с нарушением целостности кожи, включает извлечение и анализ части воспаленного лимфоузла. Этот подход может вызвать осложнения, поэтому его применение при лимфадените строго регламентировано.
Показания для биопсии лимфатического узла:
- подозрение на опухоль в увеличенном лимфоузле;
- хронические лимфадениты;
- подозрение на специфический лимфаденит;
- отсутствие эффекта от лечения (при остром или хроническом лимфадените).
Процедура выполнения
Биопсия проводится в стерильных условиях операционной с местным или общим обезболиванием.
Методы получения образца из воспаленных лимфатических узлов:
- Пункционная биопсия. В лимфоузел вводится полая игла для извлечения части тканей.
- Тонкоигольная аспирационная биопсия. Используется тонкая игла (менее 1 мм), соединенная с шприцем. Игла вводится в лимфатический узел (часто под контролем УЗИ), после чего производится аспирация ткани для анализа.
Результаты анализа
Извлеченный материал отправляется в лабораторию, где его окрашивают и исследуют под микроскопом. Это позволяет выявить опухолевые клетки и оценить степень воспаления: преобладание лимфоцитов указывает на вирусное поражение, а нейтрофилов — на бактериальную инфекцию.
Также проводится посев материала на питательные среды для роста микроорганизмов. Образец помещается в термостат для создания условий размножения бактерий. Если инфекционный агент присутствует, он начнет размножаться, и на среде появятся колонии. Это позволяет определить вид возбудителя и его чувствительность к антибиотикам, что поможет в выборе эффективного лечения.
Лечение лимфаденита
Лимфаденит указывает на инфекцию в определенной области организма. Для устранения воспаления необходимо ликвидировать источник инфекции. Игнорировать воспалительный процесс нельзя, так как он может усугубиться и привести к серьезным осложнениям.
К какому доктору обращаться?
При болезненном увеличении лимфатических узлов необходимо обратиться к семейному врачу. Специалист проведет обследование пораженной области, осмотрит другие группы лимфатических узлов, назначит лабораторные исследования и, при необходимости, направит к узким специалистам.
В зависимости от локализации и типа лимфаденита могут потребоваться консультации:
- Оториноларинголога (ЛОРа) и/или стоматолога – при воспалении подчелюстных и шейных лимфоузлов.
- Уролога – при воспалении паховых лимфоузлов.
- Терапевта – при воспалении лимфатических узлов в грудной или брюшной полости (выявленном с помощью инструментальной диагностики).
- Дерматолога – при хронических инфекциях кожи.
- Фтизиатра – при туберкулезном лимфадените.
- Хирурга – при признаках гнойного процесса в воспаленных лимфоузлах.
Основные подходы к лечению лимфаденита:
- медикаментозная терапия;
- физиотерапевтические процедуры;
- народные средства;
- хирургическое вмешательство.
Медикаментозное лечение
Принципы медикаментозного лечения лимфаденита включают этиотропную терапию для устранения первичных очагов инфекции и симптоматическую терапию для снижения воспалительных проявлений и улучшения состояния пациента.
Медикаментозное лечение лимфаденита
| Симптоматическая терапия | ||||
| Группа препаратов | Представители | Механизм действия | Способы применения и дозировка | |
| Нестероидные противовоспалительные средства | Кеторолак | Угнетает циклооксигеназу, снижая образование простагландинов, что уменьшает воспаление, боль и жар. | Принимать внутрь после еды с теплой водой или молоком. Доза – 5–10 мг 3–4 раза в день, максимум 40 мг в сутки. Курс – до 5 дней. | |
| Нимесулид (Нимесил) | Препарат нового поколения, избирательно угнетающий циклооксигеназу в области воспаления, минимизируя побочные эффекты. | Принимается внутрь в виде порошка, растворенного в 100 мл горячей воды. Доза – 100 мг (1 пакетик) 2 раза в день, курс – до 10 дней. | ||
| Антигистаминные препараты | Цетиризин | Блокирует H1-гистаминовые рецепторы, сужая сосуды и снижая проницаемость капилляров, что уменьшает отек и воспаление. | Принимать внутрь с теплой водой. Дозы: детям до 6 лет – 2,5 мг 2 раза в день; старше 6 лет и взрослым – 5 мг 2 раза в день. | |
| Этиотропная терапия | ||||
| Антибактериальные препараты | Амоксиклав | Состоит из амоксициллина и клавулановой кислоты. Амоксициллин блокирует синтез клеточной стенки бактерий, клавулановая кислота защищает его от разрушения. | Принимать внутрь через 15 минут после еды. Дозы: детям 1–2 года – 60 мг 3 раза в сутки; 2–7 лет – 125 мг 3 раза; 7–12 лет – 250 мг 3 раза; старше 12 лет и взрослым – до 300–500 мг 3 раза. Курс – 7–10 дней. | |
| Цефтриаксон | Синтетический антибиотик широкого спектра, устойчивый к бета-лактамазам, нарушает формирование клеточных мембран бактерий. | Вводится внутримышечно или внутривенно. Дозы: детям до 12 лет – 20–80 мг/кг 1 раз в сутки; старше 12 лет и взрослым – 1–2 грамма 1 раз в сутки. Курс – не менее 1 недели. | ||
| Клиндамицин | Связывается с рибосомами, угнетая деление бактерий. | Принимать внутрь после еды. Дозы: детям – 3–6 мг/кг 3 раза в сутки; взрослым – 150 мг каждые 6 часов. Курс – не менее 10 дней. | ||
| Бензилпенициллин | Производное пенициллина для лечения специфического лимфаденита при сифилисе, подавляет синтез клеточной стенки бактерий. | Вводится внутривенно или внутримышечно. Дозы: детям – 25–100 тыс. ЕД/кг 2–4 раза в сутки; взрослым – 1–1,5 млн ЕД 4 раза в сутки. | ||
| Противовирусные препараты | Ацикловир | Встраивается в вирусную ДНК, нарушая размножение вируса. Назначается при вирусном лимфадените. | Внутрь, 200–500 мг 4–5 раз в сутки. Минимальный курс – 10 дней. | |
| Римантадин | Подавляет репродукцию вирусов и стимулирует иммунитет. Назначается при лимфадените, вызванном вирусами гриппа и герпеса. | Внутрь после еды. Дозы: детям до 10 лет – 5 мг/кг 1 раз в сутки; старше 10 лет и взрослым – 100 мг 2 раза в сутки. | ||
| Противотуберкулезные препараты | Этамбутол | Угнетает синтез РНК в микобактериях туберкулеза, прекращая их размножение. | Внутрь, 1 раз в сутки, за 30 минут до еды, 15–25 мг/кг. Длительность – несколько месяцев. | |
| Рифампицин | Подавляет синтез белков в бактериальных клетках, включая микобактерии туберкулеза. | Принимать натощак, за 30 минут до еды. Дозы: детям – 10–20 мг/кг/сутки; взрослым – 450–600 мг в сутки. Курсы – от нескольких месяцев до нескольких лет. | ||
| Капреомицин | Подавляет синтез белков в микобактериях туберкулеза, останавливая их размножение. | Вводится внутримышечно или внутривенно, 15–20 мг/кг/сутки. Курс – несколько лет с изменением дозировки. | ||
| Противогрибковые препараты | Флуконазол | Нарушает синтез компонентов мембран грибов, препятствуя их росту. | Внутрь, 200–400 мг 1 раз в сутки. Длительность зависит от типа инфекции. | |
| Амфотерицин В | Нарушает проницаемость мембран грибов, приводя к их гибели. | Вводится внутривенно, капельно. Рекомендуемая доза – 0,25–0,3 мг/кг. |
Физиотерапия
Физиотерапия воздействует на организм с помощью физических факторов для достижения лечебного эффекта. Применение физиотерапевтических методов при лимфадените улучшает состояние пациента, снижает воспаление в лимфоузлах и ускоряет восстановление тканей.
Методы физиотерапии при лимфадените:
- ультравысокочастотная (УВЧ) терапия;
- лазеротерапия;
- гальванизация.
УВЧ-терапия
Метод основан на воздействии высокочастотного электромагнитного поля, что повышает температуру в области воздействия, расширяет сосуды и способствует миграции лейкоцитов к воспалению, а также образованию соединительной ткани. Эти эффекты усиливают местный иммунитет и ускоряют разрешение воспаления.
УВЧ-терапия показана при остром воспалении лимфатических узлов. Противопоказания включают подозрение на опухоли и специфический туберкулезный лимфаденит. Не рекомендуется применять метод при общем инфекционном процессе, сопровождающемся повышением температуры, ознобом, учащенным сердцебиением и мышечными болями.
Лазеротерапия
Метод основан на воздействии световых волн определенной длины на ткани. Это улучшает микроциркуляцию в воспаленном лимфоузле, оказывает противовоспалительное и обезболивающее действие, а также стимулирует восстановление.
Лазеротерапия назначается при острых и хронических лимфаденитах. Противопоказания аналогичны УВЧ-терапии. Также следует избегать воздействия лазера на участки кожи с доброкачественными новообразованиями, такими как родинки и пигментные пятна.
Гальванизация
Метод включает воздействие постоянным электрическим током низкой силы (до 50 миллиампер) и низкого напряжения (30–80 вольт), что вызывает физиологические реакции. Он оказывает местное обезболивающее действие, улучшает микроциркуляцию и способствует восстановлению поврежденных тканей и нервных волокон.
Гальванизация используется на этапе восстановления после устранения причины лимфаденита и снижения воспаления в лимфоузлах, а также при хронических формах заболевания.
Народные методы лечения
Народные методы лечения помогают облегчить симптомы воспаления лимфоузлов, улучшить общее состояние и ускорить выздоровление. Однако их следует использовать только в сочетании с антибактериальной терапией и после выяснения причины увеличения лимфоузлов. Наилучшие результаты достигаются на ранних стадиях неспецифического лимфаденита, когда воспаление выражено слабо.
Популярные народные методы лечения лимфаденита:
- прогревание лимфоузлов;
- травяные настои;
- настойка эхинацеи.
Прогревание лимфоузлов
Эффективно на начальных стадиях лимфаденита и в период восстановления. Перед применением проконсультируйтесь с врачом о природе увеличения лимфатических узлов.
Прогревание противопоказано:
- при опухолях в лимфоузлах;
- при туберкулезном лимфадените;
- при аденофлегмоне;
- при признаках интоксикации (повышение температуры, головные и мышечные боли, учащенное сердцебиение).
При неспецифическом лимфадените лимфоузлы прогревают с использованием сухого тепла. Для этого нагрейте крупный песок или соль на сковороде, поместите в тканевый мешок и приложите к воспаленному участку на 15-20 минут. После процедуры оберните место прогрева теплым платком, чтобы избежать переохлаждения. Повторяйте 2-3 раза в день, но не дольше 5-7 дней.
Если лимфоузлы продолжают увеличиваться, температура повышается или самочувствие ухудшается, прекратите прогревание и обратитесь к врачу.
Травяные настои
Противовоспалительные и антимикробные свойства растений применяются для лечения лимфаденита.
Рекомендуемые настои:
- Настой корней одуванчика. 10 г измельченных корней залить стаканом кипятка, настоять 4 часа, процедить и принимать по 1 столовой ложке 3-4 раза в день.
- Настой цветков крапивы. 5 столовых ложек сухих цветков залить 1 литром кипятка, настоять 2 часа, процедить и принимать по 100 мл 2 раза в день. Обладает противовоспалительным эффектом и способствует выведению токсинов.
- Сок алоэ. Измельчите листья алоэ, отожмите сок. К 100 г сока добавьте 200 г меда и настоите 1 день. Принимайте по 1 чайной ложке 2 раза в день. Обладает противовоспалительным и антимикробным действием.
Настойка эхинацеи
Эхинацея стимулирует иммунитет и повышает устойчивость к патогенным микроорганизмам.
Положительные эффекты эхинацеи при лимфадените:
- усиление миграции лимфоцитов в область воспаления;
- повышение фагоцитарной активности лейкоцитов;
- облегчение выделения биологически активных веществ в очаге воспаления.
Настойку эхинацеи можно купить в аптеке или приготовить самостоятельно. Для этого 100 г сухих корней залейте 500 мл 60% спирта и настаивайте 14 дней в темном месте. Процедите и храните в защищенном от света месте при температуре не выше 20ºС.
Способы применения настойки эхинацеи:
- Наружно. Разбавьте 10-20 мл настойки теплой (не горячей) водой в соотношении 1:2, смочите бинт и приложите компресс к воспаленному участку на ночь. Не используйте более 5-7 дней.
- Внутрь. Взрослым по 20-40 капель настойки, растворенной в 100 мл теплой воды, 1-2 раза в день. Доза для детей – 5-10 капель 1-2 раза в день.
Хирургические методы лечения
Хирургическое вмешательство необходимо при гнойных осложнениях лимфаденита, таких как абсцесс и аденофлегмона. Операция проводится под местной или общей анестезией и включает вскрытие гнойного очага, удаление гноя и пораженных тканей. Во время вмешательства оценивается степень распространения гнойного процесса и уровень поражения соседних органов. После завершения операции гнойный очаг промывают антисептическими растворами, например, фурацилином, затем рана ушивается и дренируется. В полость раны устанавливается дренаж для оттока воспалительной жидкости и гноя, а также для введения антисептических растворов.
Воспаление лимфоузлов – симптомы, причины, осложнения и что делать?
Лимфодренаж
Вопрос-ответ
Каковы причины лимфаденита?
Лимфаденит может быть вызван различными факторами, включая инфекционные агенты (бактерии, вирусы, грибки), воспалительные процессы, травмы или опухоли. Наиболее распространенными причинами являются бактериальные инфекции, такие как стрептококки и стафилококки, а также вирусные инфекции, например, мононуклеоз. Кроме того, лимфаденит может развиваться в результате хронических заболеваний, таких как туберкулез или сифилис.
Какие лекарства пьют при лимфадените?
При лимфадените лечение зависит от причины заболевания. В большинстве случаев применяются противовоспалительные препараты, такие как ибупрофен или парацетамол, для снятия боли и уменьшения воспаления. Если лимфаденит вызван бактериальной инфекцией, могут быть назначены антибиотики. Важно обратиться к врачу для точной диагностики и назначения соответствующего лечения.
- Бактериальные инфекции. Бактериальный лимфаденит вызывают стрептококки, стафилококки, пневмококки, кишечная или туберкулезная палочка.
Советы
СОВЕТ №1
Если вы заметили увеличение лимфатических узлов, не откладывайте визит к врачу. Раннее обращение поможет установить причину и начать лечение на ранней стадии, что значительно повысит шансы на быстрое выздоровление.
СОВЕТ №2
Обратите внимание на сопутствующие симптомы, такие как лихорадка, потливость, усталость или боль в области лимфатических узлов. Эти признаки могут помочь врачу в диагностике и выборе правильного лечения.
СОВЕТ №3
Не занимайтесь самолечением. При лимфадените важно следовать рекомендациям врача и не использовать антибиотики или другие препараты без назначения, так как это может усугубить состояние.
СОВЕТ №4
Поддерживайте здоровый образ жизни: сбалансированное питание, регулярные физические нагрузки и достаточный сон помогут укрепить иммунную систему и снизить риск развития инфекций, которые могут привести к лимфадениту.